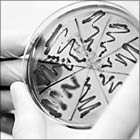

Алматинские прокуроры недавно выявили группу предприимчивых граждан, которые получали пособия от государства из-за якобы без вести пропавших кормильцев. Сами “кормильцы”, как выяснилось, никуда не пропадали.
 Бибигуль Имангазина намерена воевать с Тимуром Кулибаевым до победного конца
Бибигуль Имангазина намерена воевать с Тимуром Кулибаевым до победного конца
Скандалом закончилась встреча президента общества женщин-инвалидов “Биби-Ана” Бибигуль ИМАНГАЗИНОЙ и ее сторонников с представителями ТОО “АлматыГазИнжиниринг” и нескольких общественных организаций, прошедшая в четверг в Алматы.
 Движение “Коммунисты Казахстана” требует отменить Единое национальное тестирование. Об этом нам вчера сообщил представитель движения, депутат маслихата Восточно-Казахстанской области Александр ТЮМЕНЦЕВ.
Движение “Коммунисты Казахстана” требует отменить Единое национальное тестирование. Об этом нам вчера сообщил представитель движения, депутат маслихата Восточно-Казахстанской области Александр ТЮМЕНЦЕВ.
 В Алматы создан общественный комитет в защиту газеты “Взгляд”, которую суд обязал выплатить бывшему хирургу 4-й горбольницы Адилю КЕЛЬДЫБАЕВУ 15 миллионов тенге. В комитет вошли представители политических партий и неправительственных организаций, правозащитники и общественные деятели.
В Алматы создан общественный комитет в защиту газеты “Взгляд”, которую суд обязал выплатить бывшему хирургу 4-й горбольницы Адилю КЕЛЬДЫБАЕВУ 15 миллионов тенге. В комитет вошли представители политических партий и неправительственных организаций, правозащитники и общественные деятели.
С 1 июня стоимость проезда в павлодарских трамваях выросла на пятачок - до 40 тенге. Через месяц, с 1 июля, такая же участь постигнет автобусы. Маршрутные такси довезут за 45 тенге.
 В середине мая на театральных подмостках Британии состоялась премьера трагедии Шекспира “Макбет” на казахском языке. Студенты Национальной академии искусств имени Т. Жургенова под руководством заслуженного деятеля РК профессора Оразхана КЕНЕБАЕВА имели огромный успех на туманном Альбионе. В понедельник, 6 июня, ребята покажут эту постановку на сцене Казахского театра драмы им. М. Ауэзова.
В середине мая на театральных подмостках Британии состоялась премьера трагедии Шекспира “Макбет” на казахском языке. Студенты Национальной академии искусств имени Т. Жургенова под руководством заслуженного деятеля РК профессора Оразхана КЕНЕБАЕВА имели огромный успех на туманном Альбионе. В понедельник, 6 июня, ребята покажут эту постановку на сцене Казахского театра драмы им. М. Ауэзова.
 Пропасть между богатыми и бедными в некоторых странах бывшего СССР может привести в них к крушению всего и вся
Пропасть между богатыми и бедными в некоторых странах бывшего СССР может привести в них к крушению всего и вся
Три четверти населения России - бедняки, зато по количеству миллиардеров и мультимиллионеров она занимает пятое место в мире - таковы обнародованные на этой неделе данные двух исследований. Эксперты говорят, что это расслоение мешает развитию страны и делает внутреннее положение опасно неустойчивым.
Опасную кишечную инфекцию в Европе, жертвами которой стали уже 18 человек, вызвал новый мутировавший штамм, сообщает Associated Press со ссылкой на представителей Всемирной организации здравоохранения (ВОЗ).
Опасную кишечную инфекцию в Европе, жертвами которой стали уже 18 человек, вызвал новый мутировавший штамм, сообщает Associated Press со ссылкой на представителей Всемирной организации здравоохранения (ВОЗ).
 Израильский гроссмейстер Борис Гельфанд - некогда наш соотечественник - стал официальным претендентом на мировую шахматную корону
Израильский гроссмейстер Борис Гельфанд - некогда наш соотечественник - стал официальным претендентом на мировую шахматную корону
На прошлой неделе Борис ГЕЛЬФАНД (на снимке) выиграл матч-турнир в Казани, победив в финале со счетом 3,5:2,5 россиянина Александра ГРИЩУКА. Теперь один из самых стабильных шахматистов мира оспорит право на титул чемпиона мира у его действующего обладателя Виши АНАНДА из Индии. Матч между Гельфандом и Анандом пройдет в 2012 году, место его проведения определит ФИДЕ. Мы позвонили Борису в Израиль и “сыграли” с ним блиц - записали короткое интервью.
 Чемпион WBA в полутяжелом весе (79,4 кг) Бейбут ШУМЕНОВ стремится к объединительным боям в рамках своей весовой категории. Однако если 27-летнему казахстанскому боксеру не удастся договориться ни с одним из действующих чемпионов, то он хотел бы встретиться с не знающим поражений экс-чемпионом мира в двух весовых категориях 37-летним венгром Золтаном ЭРДЕИ.
Чемпион WBA в полутяжелом весе (79,4 кг) Бейбут ШУМЕНОВ стремится к объединительным боям в рамках своей весовой категории. Однако если 27-летнему казахстанскому боксеру не удастся договориться ни с одним из действующих чемпионов, то он хотел бы встретиться с не знающим поражений экс-чемпионом мира в двух весовых категориях 37-летним венгром Золтаном ЭРДЕИ.
 Определились все участники Кубка президента РК по хоккею, который пройдет в Астане 9-13 августа.
Определились все участники Кубка президента РК по хоккею, который пройдет в Астане 9-13 августа.
 Казахстанско-американскому дуэту Ярослава ШВЕДОВА - Ваниа КИНГ в парном разряде серии Большого шлема - “Ролан Гаррос” не удалось выйти в финал теннисного турнира во Франции. В полуфинале Шведова и Кинг были биты в двух партиях чешским тандемом Андреа ХЛАВАКОВА - Люси ХЛАДЕСКА - 6:3, 6:3.
Казахстанско-американскому дуэту Ярослава ШВЕДОВА - Ваниа КИНГ в парном разряде серии Большого шлема - “Ролан Гаррос” не удалось выйти в финал теннисного турнира во Франции. В полуфинале Шведова и Кинг были биты в двух партиях чешским тандемом Андреа ХЛАВАКОВА - Люси ХЛАДЕСКА - 6:3, 6:3.
В Голландии завершился VII этап международных соревнований по легкой атлетике - “Мировой вызов”.
 Почти в половине из 25 проверенных киосков и магазинов Алматы подростки смогли легко приобрести пиво. Таковы итоги акции “Пивной дозор”, которая прошла в южной столице в четверг.
Почти в половине из 25 проверенных киосков и магазинов Алматы подростки смогли легко приобрести пиво. Таковы итоги акции “Пивной дозор”, которая прошла в южной столице в четверг.

 4 июня, суббота
4 июня, суббота
День государственных символов Казахстана
4 июня 1992 года были утверждены государственные символы независимого Казахстана.
Голубой флаг с золотистым солнцем и парящим силуэтом орла и герб, в центре которого находится образ шанырака как символ общего дома для всех казахстанцев, явили миру образ нового независимого государства под названием Республика Казахстан.
 ОВЕН. Отличный день для домашних дел, семейных покупок, коротких выездов на природу. Однако не исключается и срочный вызов на службу, тогда вам придется там поработать, если не найдется замены.
ОВЕН. Отличный день для домашних дел, семейных покупок, коротких выездов на природу. Однако не исключается и срочный вызов на службу, тогда вам придется там поработать, если не найдется замены.
Ограблена квартира депутата парламента. По словам депутата, у него ничего не пропало. А вот у его жены было украдено два миллиона долларов.
***
Разговаривают два алкоголика:
- Оказывается Фолкнер, Хемингуэй, Эдгар По и другие писатели были хроническими алкоголиками.
- Я всегда тебе говорил, что у нас отличная компания.
 На юриста профсоюза нефтяников Каражанбаса в Мангистауской области Наталью СОКОЛОВУ (на снимке) завели уголовное дело по части 3 статьи 164 (возбуждение социальной, национальной, родовой, расовой или религиозной вражды) УК РК. Теперь активистке светит от 3 до 10 лет лишения свободы.
На юриста профсоюза нефтяников Каражанбаса в Мангистауской области Наталью СОКОЛОВУ (на снимке) завели уголовное дело по части 3 статьи 164 (возбуждение социальной, национальной, родовой, расовой или религиозной вражды) УК РК. Теперь активистке светит от 3 до 10 лет лишения свободы.
В столице Казахстана Астане теперь каждую субботу будут проводиться массовые зарядки в рамках акции “Зарядись энергией жизни”, сообщает управление туризма, физкультуры и спорта города.
О том, как повышать рождаемость в стране и кто еще на это способен, на пленарном заседании в среду выясняли депутаты мажилиса.